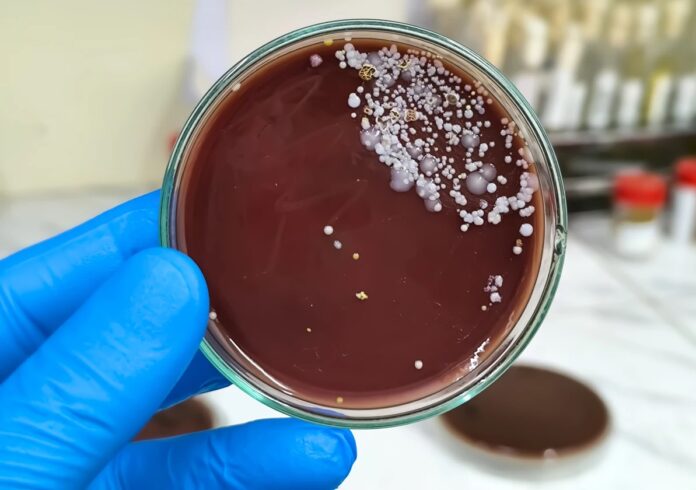

Dois surtos do “superfungo” Candida auris fizeram a Agência Nacional de Vigilância Sanitária (Anvisa) emitir um alerta de risco para que casos suspeitos sejam encaminhados imediatamente para os Laboratórios Centrais de Saúde Pública (Lacen) de cada estado.
Os surtos registrados este ano foram em um hospital de São Paulo, onde 14 casos foram confirmados, e em um hospital de Recife, onde outros quatro casos foram confirmados. De acordo com a Anvisa, por ser uma “séria ameaça à saúde pública”, uma ocorrência de Candida auris em um serviço de saúde no país já é considerado surto.
Para conter a contaminação, o alerta da Anvisa, publicado no mês passado, recomendou a intensificação da vigilância laboratorial para a identificação do fungo, o reforço das medidas de prevenção e controle de infeccções e a atualização de procedimentos de isolamento, limpeza e desinfecção das unidades de saúde.
Na Bahia, de acordo com a Secretaria de Saúde do Estado (Sesab), não há casos registardos do “superfungo” este ano.
Primeiro caso surgiu entre baianos
O primeiro registro da Candida auris no país aconteceu em 2020, em Salvador. O surto registrado entre os baianos chegou a 15 casos confirmados. No ano seguinte, mais um caso foi registrado na capital baiana.
Em 2022, foram notificados surtos em dois hospitais de Recife, um deles com 47 casos confirmados, o maior surto do fungo no Brasil.
Outros seis surtos foram registrados no estado de Pernambuco em 2023, com 14 casos confirmados. No mesmo ano, o estado de São Paulo teve seu primeiro surto, em Campinas, com um caso confirmado. O mesmo aconteceu com o Rio de Janeiro, que teve o primeiro caso confirmado em Nova Iguaçu.
Em 2024, um surto com quatro casos confirmados aconteceu em Belo Horizonte. Além de dois novos surtos em Pernambuco, com mais dez casos, e um novo surto na Bahia, com um caso.
Organismo super resistente
A Candida auris é um fungo emergente que representa uma séria ameaça por que, segundo explicou a Anvisa, apresenta resistência aos medicamentos comumente utilizados para tratar infecções por Candida.
Além disso, pode causar infecção de corrente sanguínea e outras infecções invasivas, podendo ser fatal, principalmente em pacientes imunodeprimidos ou com comorbidades.
O “superfungo” também consegue permanecer ativo por longos períodos no ambiente, por semanas ou até meses, Ele também apresenta resistência a diversos desinfetantes, até aqueles que são à base de quaternário de amônio.
O organismo também tem a propensão em causar surtos em decorrência da dificuldade de identificação. Isso porque, muitos laboratórios do país não possuem capacidade e recursos para identificar adequadamente espécies de Candida, dificultando a adoção de medidas de controle.
Correio24h